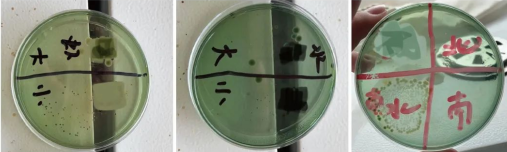
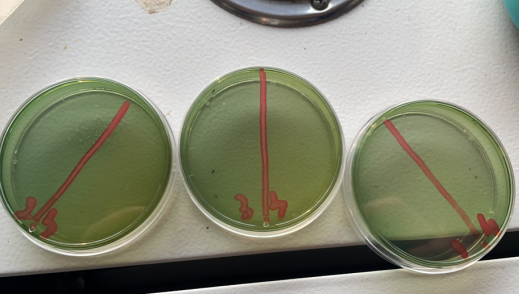

由于水源问题今年的小棚标粗弧菌严重超标,明显比前些年来得早,来的快,很多养殖户在弧菌方面不重视,吃了大亏!
2023年4月18号
地区:天津市宝坻区大唐庄镇
品种:小棚标粗
放苗5天左右,水温23℃,提拍发现有死苗,弱苗,并伴随吃料慢,搂网发现有偷死虾,问题比较严重,水体肥度很好,指标也正常,经弧菌培养发现绿弧菌超标。
x防治方案:使用中仁绿弧克星每桶拌料20斤,连续投喂3天,外泼弧立净每瓶一亩水体,隔天使用光合细菌布菌。
使用后回访,弧菌明显减少,虾苗不在偷死,吃料恢复正常!
总结:弧菌问题不容小觑,每年都有很多工厂因为弧菌导致排池,造成了很大的损失,随着温度升高,喂料的增加,弧菌会大量繁殖,建议养殖户提早防控,小棚水体可用50%过硫酸氢钾复合盐泡腾颗粒(200g)每袋1亩地进行消毒,随后补充光合细菌(每瓶1亩),然后定期饲喂绿弧克星每桶40斤料进行预防,定期可用弧立净外泼一亩地防控水体。


本文供稿:温佳鑫
编辑审核:臧学运,张传宝